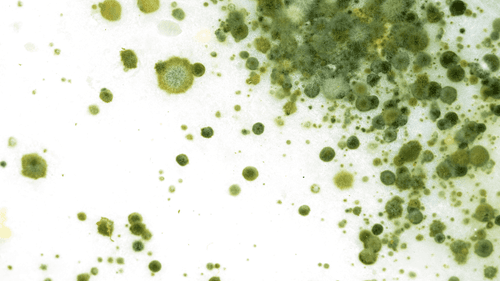
Fungo da cannabis revela potencial antibacteriano e antioxidante

Com produtos distribuídos em 7 mil pontos de venda no Brasil, empresa reforça modelo verticalizado na Colômbia, amplia autorizações da Anvisa e estrutura pipeline de lançamentos até 2032

Inspirado no formato do Pint of Science, que leva discussões científicas para espaços não formais, o Comitiva de Ponta se apresenta como um hub de tecnologia social e medicinal. O objetivo é aproximar ciência, empresas do setor, associações de pacientes, artistas e a sociedade civil, promovendo acesso à informação qualificada e reduzindo estigmas relacionados à cannabis

Nova diretriz cria marco legal para cultivo, processamento e comercialização da planta com foco industrial e medicinal

Evento que reúne formuladores de políticas, investidores e líderes da indústria consolida-se como o principal fórum estratégico da cannabis legal na Europa e antecipa os rumos do mercado em 2026

Congresso será realizado de 21 a 23 de maio, em São Paulo, e reúne política pública, ciência, mercado e inovação no principal encontro da América Latina.

Entre normas sanitárias e repressão penal, pacientes que cultivam cannabis para fins medicinais enfrentam insegurança jurídica, seletividade e omissão legislativa. A advogada criminalista Paloma Cassimiro Faustino analisa como o vazio regulatório transforma o direito à saúde em risco de prisão

Evento gratuito acontece no dia 28 de março, no Parque Oriental, e reúne especialistas, associações, poder público e comunidade para debater acesso à cannabis medicinal, políticas públicas e desenvolvimento no ABC Paulista

Dados oficiais indicam retomada em volume após restrição às consultas remotas, mas queda nos preços pressiona faturamento do setor

Projeto apresentado no Legislativo estadual propõe uso adulto, programa medicinal e novas regras para produtos derivados do cânhamo

Da descoberta terapêutica no tratamento da endometriose à criação da Psicocannabis, psicóloga constrói uma rede de formação e acolhimento em saúde mental

Com respaldo científico e acompanhamento profissional, a cannabis medicinal avança na medicina veterinária e amplia possibilidades terapêuticas para cães e gatos no Brasil, como mostra o Guia Sechat 2025

Levantamento indica que apoio à legalização de substâncias como psilocibina se aproxima do patamar registrado para a cannabis antes das primeiras mudanças regulatórias estaduais

Em entrevista ao Deusa Cast, a CEO da Conecta Cann detalha como as novas resoluções da Anvisa impõem padrões industriais e por que o Brasil se posiciona como hub global de IFA

Os dois países estão a avançar em modelos regulatórios que priorizam preparações padronizadas e controle farmacêutico da cannabis medicinal nos sistemas de saúde

Dados oficiais mostram que o varejo de cannabis no Canadá alcançou C$ 503,7 milhões em dezembro, estabelecendo o maior resultado mensal desde a legalização

Pesquisa sul-coreana analisou, em laboratório, como extratos de cannabis ricos em CBG atuam em mecanismos ligados ao acúmulo de gordura

Pesquisa in vitro indica que o tetrahidrocanabinol inibe o crescimento do Streptococcus mutans e reduz seu potencial cariogênico, ampliando as evidências sobre a eficiência medicinal da cannabis

Jogadores da Portuguesa recebem tratamento com CBD para reduzir dores musculares e acelerar recuperação física

Segundo a Anvisa, produção e cultivo passam a ter regras específicas; STF mantém descriminalização do porte para uso pessoal

Medidas em análise no Colorado, Hawaii, Virginia e Washington tratam do acesso à cannabis medicinal em unidades de saúde

A atriz e apresentadora Whoopi Goldberg participou de um evento sobre o mercado legal da cannabis em Nova Jersey e abordou temas como bem-estar, saúde da mulher e os desafios culturais que ainda cercam a planta nos Estados Unidos

Estudo detalha como a ibogaína e seu metabólito noribogaína modulam múltiplos transportadores nas sinapses serotoninérgicas, ampliando a compreensão sobre seus mecanismos de ação no cérebro

País avança na regulamentação da cannabis medicinal após fase experimental e define regras sobre prescrição, produtos e reembolso no sistema público de saúde

Nos EUA, varejistas registraram picos de vendas antes de tempestades de neve, com faturamento superior até mesmo a datas tradicionais do setor

Empresário Joaquim Castro afirma que o avanço do cultivo nacional e a revisão da RDC 660 serão determinantes para preços, concorrência, importação e acesso de pacientes no Brasil

Nova colocação eletiva para alunos de Medicina marca avanço no ensino formal sobre sistema endocanabinoide e prescrição no Reino Unido

Após aprovação de uma ordenança que restringia a venda de produtos com THC derivado do cânhamo, o prefeito de Chicago vetou a medida e reacendeu o debate sobre regulação, economia local e acesso ao mercado na cidade

Pesquisa mostra que modelos de linguagem conseguem simular experiências psicodélicas com alto realismo textual, mas sem vivência real — e isso levanta preocupações de segurança.
Pesquisa publicada na Natural Product Research revela potencial farmacêutico de fungo isolado da Cannabis sativa

Da abertura regulatória à seleção técnica: o setor canábico brasileiro inicia um novo ciclo marcado por verticalização, rastreabilidade e maior maturidade em Life Sciences